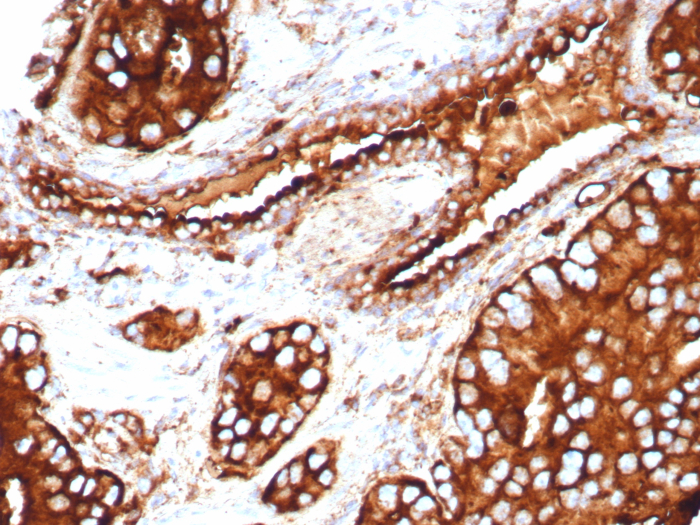
CD63 Antibody (LAMP3/8705R)

CD63 Antibody (LAMP3/8705R)
Novus Biologicals, part of Bio-Techne | Catalog # NBP3-20500
Recombinant Monoclonal Antibody


Conjugate
Catalog #
Forumulation
Catalog #
Key Product Details
Species Reactivity
Human
Applications
Immunohistochemistry-Paraffin
Label
Unconjugated
Antibody Source
Recombinant Monoclonal Rabbit IgG Kappa Clone # LAMP3/8705R
Concentration
0.2 mg/ml
Product Specifications
Immunogen
Recombinant full-length human CD63 protein (recognizes extracellular epitope)
Localization
Cell Surface. Cytoplasm.
Clonality
Monoclonal
Host
Rabbit
Isotype
IgG Kappa
Description
Positive Controls: U87MG, SK-MEL-28, HL60, THP-1 or NIH/3T3 cells. Melanoma or lymphoma.
Antibody with azide - store at 2 to 8C. Antibody without azide - store at -20 to -80C. Non-hazardous. No MSDS required.
Antibody with azide - store at 2 to 8C. Antibody without azide - store at -20 to -80C. Non-hazardous. No MSDS required.
Scientific Data Images for CD63 Antibody (LAMP3/8705R)
CD63 Antibody (LAMP3/8705R)
Formalin-fixed, paraffin-embedded human placenta stained with CD63 antibody (LAMP3/8705R). Inset: PBS instead of primary antibody; secondary only negative control.CD63 Antibody (LAMP3/8705R)
Formalin-fixed, paraffin-embedded human prostate stained with CD63 antibody (LAMP3/8705R). HIER: Tris/EDTA, pH9.0, 45min. Secondary: HRP-polymer, 30min. DAB, 5min.Applications for CD63 Antibody (LAMP3/8705R)
Application
Recommended Usage
Immunohistochemistry-Paraffin
1-2 ug/ml
Application Notes
Immunohistochemistry (Formalin-fixed): 1-2ug/ml for 30 minutes. at RT. Staining of formalin-fixed tissues requires heating tissue sections in 10mM Tris with 1mM EDTA, pH 9.0, for 45 min at 95C followed by cooling at RT for 20 minutes.
Optimal dilution for a specific application should be determined.
Optimal dilution for a specific application should be determined.
Formulation, Preparation, and Storage
Purification
Protein A or G purified
Formulation
10mM PBS with 0.05% BSA
Preservative
0.05% Sodium Azide
Concentration
0.2 mg/ml
Shipping
The product is shipped with polar packs. Upon receipt, store it immediately at the temperature recommended below.
Stability & Storage
Store at 4C. Do not freeze.
Background: CD63
References
1. Pols, M. S., & Klumperman, J. (2009). Trafficking and function of the tetraspanin CD63. Experimental cell research. https://doi.org/10.1016/j.yexcr.2008.09.020
2. Metzelaar, M. J., Wijngaard, P. L., Peters, P. J., Sixma, J. J., Nieuwenhuis, H. K., & Clevers, H. C. (1991). CD63 antigen. A novel lysosomal membrane glycoprotein, cloned by a screening procedure for intracellular antigens in eukaryotic cells. The Journal of biological chemistry.
3. Horejsi, V., & Vlcek, C. (1991). Novel structurally distinct family of leucocyte surface glycoproteins including CD9, CD37, CD53 and CD63. FEBS letters. https://doi.org/10.1016/0014-5793(91)80988-f
4. Eckfeld, C., HauBler, D., Schoeps, B., Hermann, C. D., & Kruger, A. (2019). Functional disparities within the TIMP family in cancer: hints from molecular divergence. Cancer metastasis reviews. https://doi.org/10.1007/s10555-019-09812-6
5. Hoffmann, H. J., Santos, A. F., Mayorga, C., Nopp, A., Eberlein, B., Ferrer, M., Rouzaire, P., Ebo, D. G., Sabato, V., Sanz, M. L., Pecaric-Petkovic, T., Patil, S. U., Hausmann, O. V., Shreffler, W. G., Korosec, P., & Knol, E. F. (2015). The clinical utility of basophil activation testing in diagnosis and monitoring of allergic disease. Allergy. https://doi.org/10.1111/all.12698
6. Dell'Angelica, E. C., Shotelersuk, V., Aguilar, R. C., Gahl, W. A., & Bonifacino, J. S. (1999). Altered trafficking of lysosomal proteins in Hermansky-Pudlak syndrome due to mutations in the beta 3A subunit of the AP-3 adaptor. Molecular cell. https://doi.org/10.1016/s1097-2765(00)80170-7
Alternate Names
CD63, Granulophysin, Lamp-3, ME491, OMA81H, Tspan30
Gene Symbol
CD63
Additional CD63 Products
Product Documents for CD63 Antibody (LAMP3/8705R)
Product Specific Notices for CD63 Antibody (LAMP3/8705R)
This product is for research use only and is not approved for use in humans or in clinical diagnosis. Primary Antibodies are guaranteed for 1 year from date of receipt.
Loading...
Loading...
Loading...
Loading...